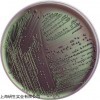

| 提交询价信息 |
| 发布紧急求购 |

价格:电议
所在地:上海
型号:
更新时间:2018-12-14
浏览次数:1059
公司地址:上海市漕宝路66号20F
![]()
刘小姐(女士)
中文名称:NBB培养基规格
英文名称: NBB Agar
产品规格: 250g
产品用途:用于啤酒中厌氧菌检测

用于啤酒中厌氧菌检测
用法
称取本品 66.3g,加入 500ml蒸馏水和 500ml 脱气啤酒中,加热搅拌溶解,煮沸 1分钟,使其彻底溶解,121℃高压灭菌 15 分钟,备用。
NBB培养基规格的特点:
(1)MS培养基 它是1962年由Murashige和Skoog为培养烟草细胞而设计的。特点是无机盐和离子浓度较高,为较稳定的平衡溶液。其养分的数量和比例较合适,可满足植物的营养和生理需要。它的硝酸盐含量较其他培养基为高,广泛地用于植物的器官、花药、细胞和原生质体培养,效果良好。有些培养基是由它演变而来的。
(2)B5培养基 是1968年由Gamborg等为培养大豆根细胞而设计的。其主要特点是含有较低的铵,这可能对不少培养物的生长有抑制作用。从实践得知有些植物在B5培养基上生长更适宜,如双子叶植物特别是木本植物。
(3)White培养基 是1943年由White为培养番茄根尖而设计的。1963年又作了改良,称作White改良培养基,提高了MgSO4的浓度和增加了鹏素。其特点是无机盐数量较低,适于生根培养。
(4)N6培养基 是1974年朱至清等为水稻等禾谷类作物花药培养而设计的。其特点是成分较简单,KNO3和(NH4)2SO4含量高。在已广泛应用于小麦、水稻及其他植物的花药培养和其他组织培养。
(5)KM-80培养基 它是1974年为原生质体培养而设计的。其特点是有机成分较复杂,它包括了所有的单糖和维生素,广泛用于原生质融合的培养。
NBB培养基规格实验内容:
1.称量→溶化→调pH→过滤→分装→加塞→包扎→灭菌→无菌检查
2.干热灭菌:装入待灭菌物品→升温→恒温→降温→开箱取物
3.高压蒸汽灭菌:加水→装物品→加盖→加热→排冷空气→加压→恒压→降压回零→排汽→取物→无菌检查
4.过滤除菌:组装灭菌→连接→压滤→无菌检查→清洗灭菌
NBB培养基规格保存条件:
培养基由于配制的原料不同,使用要求不同,而贮存保管方面也稍有不同。一般培养基在受热、吸潮后,易被细菌污染或分解变质,因此一般培养基必须防潮、避光、阴凉处保存。对一些需严格灭菌的培养基(如组织培养基),较长时间的贮存,必须放在2~6℃的冰箱内。由于液体培养基不易长期保管,现在均改制成粉末。
5-溴噻吩-2-磺酰氯 55854-46-1
3-氟-4-甲氧基苯腈 331-62-4
2-氯-4-甲基苯甲酸 7697-25-8
3,4-二甲氧基苄腈 2024-83-1
(S)-环丙氨基乙酸 15785-26-9
2,2'-二硫二吡啶 2127/3/9
偶氮二甲酰胺 123-77-3
4-(萘-2-)苯硼酸 918655-03-5
羟甲基 874-89-5
3-(2,6-二氯-3,5-二甲氧基苯基)-1-[6-[[4-(4-乙基哌嗪-1-基)苯基]氨基]嘧啶-4-基]-1-甲基脲 872511-34-7
2,6-二氟 85068-28-6
2,6-二氟 85068-28-6
茶多酚 84650-60-2
4,4'-二氨基二苯砜 80-08-0
喹喔啉 91-19-0
四丙基溴化铵 1941-30-6
4,5-二氟-2-甲基苯甲酸 183237-86-7
6-氨基间甲酚 2835-98-5
3-溴-4-氯苯甲醛 86265-88-5
二苯甲酮腙 5350-57-2
3-氯-2-氟吡啶 1480-64-4
3-氧代-1-环戊烷羧酸 98-78-2
2-脱氧-2-氟-1,3,5-三苯甲酰基-alpha-D-阿拉伯呋喃糖 97614-43-2
1,1'-双(二异丙基膦)二茂铁 97239-80-0
(S)-4-氯-3-羟基 127913-44-4
1,4-苯并二恶烷-6-甲醛 29668-44-8
5-溴-2,3-二氯吡啶 97966-00-2
p-Hydroxyphenethyl trans-ferulate
γ-Methoxyisoeugenol
Ferulic acid
Levistilide A
Anemarsapo
1,2-Didehydromiltirone
Salvianolic acid D
Salvianolic acid H
Lithospermic acid B, Salvianolic acid B
NBB培养基规格Cryptotanshinone
Danshensu
Dihydrotanshinone I
Miltirone
Salvianolic acid A
Salvianolic acid C
Tanshinone I
Tanshinone II A
Crotaline
Anhydroglycinol
Auriculasin
1,11b-Dihydro-11b-hydroxymaackiain
1,11b-Dihydro-11b-hydroxymedicarpin
12-Deoxo-12α-acetoxyelliptone
6,8-Diprenylgenistein
Deguelin
Dehydrodeguelin
Demethylvestitol
Derrisisoflavone B
Erysenegalensein E
11-Hydroxytephrosin
3-Hydroxy-8,9-methylenedioxypterocarpene
 免责声明:以上所展示的[ NBB培养基规格]信息由会员[上海研生实业有限公司]自行提供,内容的真实性、准确性和合法性由发布会员负责。
免责声明:以上所展示的[ NBB培养基规格]信息由会员[上海研生实业有限公司]自行提供,内容的真实性、准确性和合法性由发布会员负责。